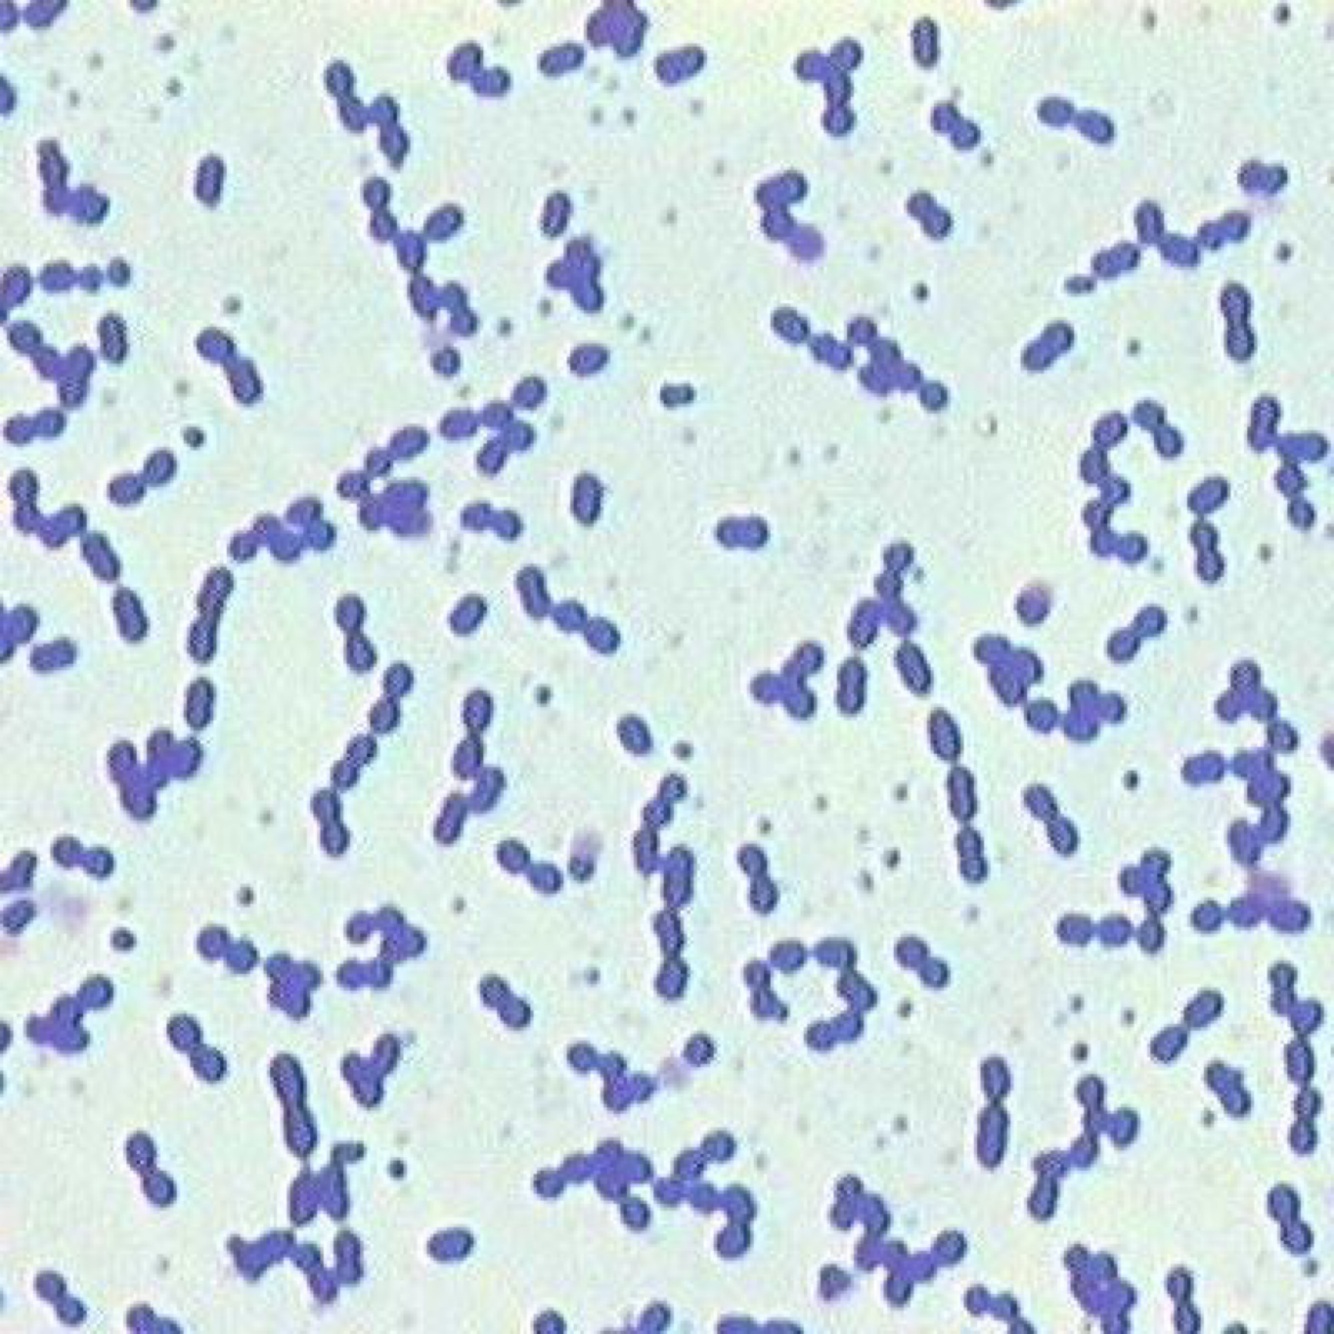

Describe the key bacterial characteristics of Strepococcus.

-gram pos cocci in chains
-facultative anaerobes
-non motile, non spore forming
-catalase (-)
-fastidious
-commensal on mucus membrane
-human & animals (host specific)
-opportunistic (secondary)
-dont survive well in environment
-acute suppurative infection (abscess)
-local & systemic infection
>ex: septicimia, LN, mastitis, pneumonia

Describe the different types of testing.
- Hemolytic
-B hemolytic (complete) [pyogenic spp]
-a hemolytic (partial) [s. Suis, s. Dysgalactiae]
-gamma hemolytic (no hemolysis) [enterococcus spp] - biochemical test: lancefield classification
>ag-ab test based on cell wall polysaccharide antigen (C substance) -> group A-H
>ring precipitation & latex agglutination test
Describe the virulence factors & pathogenesis.

Describe the species of vet imp.

Describe streptococcus equi subspecies equi.
‘Strangles, equine distemper’
-highly contagious
-URT
-abscess of submandibular & retropharyngeal LN = airway obstruction -> death
-enzootic, NOT a commensal
-transmission via purulent exudates
-can be carriers
-morbidity 100%, mortality 5%
-all ages but mostly yearlings & weaned
-incubation = 3-6d (disease is 5-10d)
-CS: fever, depression, anorexia, discharge
Describe the complications of strangles.
- Guttural pouch empyema (most common)
-secondary to URT inf
-purulent exudate in pouch
-stiff head, swelling, diff breathing - Bastard strangles (rare)
-systemic, disseminated inf w abscess in organs - Purpura haemorrhagica
-immune complex mediated vasculitis - Carriers
Describe the diagnosis & treatment for strangles.
-most recover after abscess mature & rupture = strong immunity
-diagnosis:
>CS
>culture
>serology = ELISA for anti M protein Ab
>PCR = target M protein
-treatment:
>symptomatic carrier = relieve pain & drain mature abscess
>antibiotics soon after exposure & before abscess formation (rec in bastard)
Describe the prevention of strangles.
- Vaccine not 100%
-inactive vaccine w M protein for preg mare & foal = high level of anti M protein opsonizing Ab
-intranasal vaccine to stim mucosal immunity & serum - Prevention
-isolate
-notify
-3 neg cultures weekly -> release from quarantine
Describe the phases of strangles.
- Incubatory
-nasal shed 4-7d after exposure w or w/o discharge - Clinical
-shed from sites - Convalescent
-nasal shed up to 6wks after recovery - Long term chronic shedding
Describe streptococcus suis.
-meningitis, arthritis, septicemia, bronchopneumonia
-‘nursery disease’ = affect pigs 2-5w after weaning
-sometimes endocarditis, neonatal death, abortion
-100% carriers in tonsillar tissue, disease 5%, no treatment mortality is 20%
-serotyping
-predisposing factors: ventilation, temp, bacteria, low immunity, overcrowding, stress
-zoonotic = meningitis in humans
Describe the T & P for streptococcus suis.
- Treatment
-pen or amp - Prevention
-LA pen inj to sow 1w prior to farrowing
-LA pen inj to piglets during first 2w of life
-improve husbandry & hygiene
Describe streptococcus agalactiae, s. Dysgalactiae, s. Uberis.
‘bovine streptococcal mastitis’
1. Contagious mastitis
-s. Agalactiae = colonize milk duct (obligate) -> chronic mastitis
2. Environmental mastitis
-s. Dysgalactiae = colonize buccal cavity & genitalia -> acute mastitis (commensal of skin of mammary gland)
-s. Uberis = colonize skin, tonsil, vag mucosa -> subclinical (seen in straw bedding)
more subclinical than clinical
Describe bovine streptococcal mastitis T & P.
-pre & post milk teat dipping
-sep paper towels
-reduce teat injury
-segregate chronic mastitis (cull or milk last)
-dry cow treat all
-nutrition & hygiene
-pre screening
-monitor somatic cell count in milk
Describe the etiopathology of cattle mastitis.
- Exposure to microorganisms
- Host defense mech
- Environmental conditions

Describe streptococcus equi subspecies zooepidemicus.
‘Pyogenic streptococci infections’
-opportunistic causing purulent inf in broad range of animals
-mucus membrane
-URT inf, pneumonia, mastitis, septicemia
-emerging zoonotic pathogen -> necrotizing myositis & meningitis in humans
Describe streptococcus canis.
‘Pyogenic streptococci infections’
-toxic shock syndrome
-necrotizing faciitis in dogs & cats
-commensal on skin & mucus membrane
-inf from vag or umbilical v -> peritoneal cavity -> liver -> bacteremia
-septicemia & embolic lesions in heart & lung
toxin & superantigens = lethal
Describe streptococcus pyogenes.
‘Pyogenic streptococci infections’
-mild superficial skin disease to life threatening systemic disease
-toxic shock
-flesh eating bacteria = necrotizing faciitis
-non pyogenic = fever
Describe the key bacterial characteristics of Enterococcus.
-gram pos ovoid in pairs or short chain
-facultative anaerobes
-some strains motile
-non spore forming
-catalase (-)
-commensal of GIT of human & animal
-opportunists
Describe enterococcus faecalis, E. Faecium.
‘Opportunistic infections’
-wound inf
-mastitis in cattle
-UTI & ear inf in dogs
-nosocomial inf
-antimicrobial resistance: VRE vancomycin


